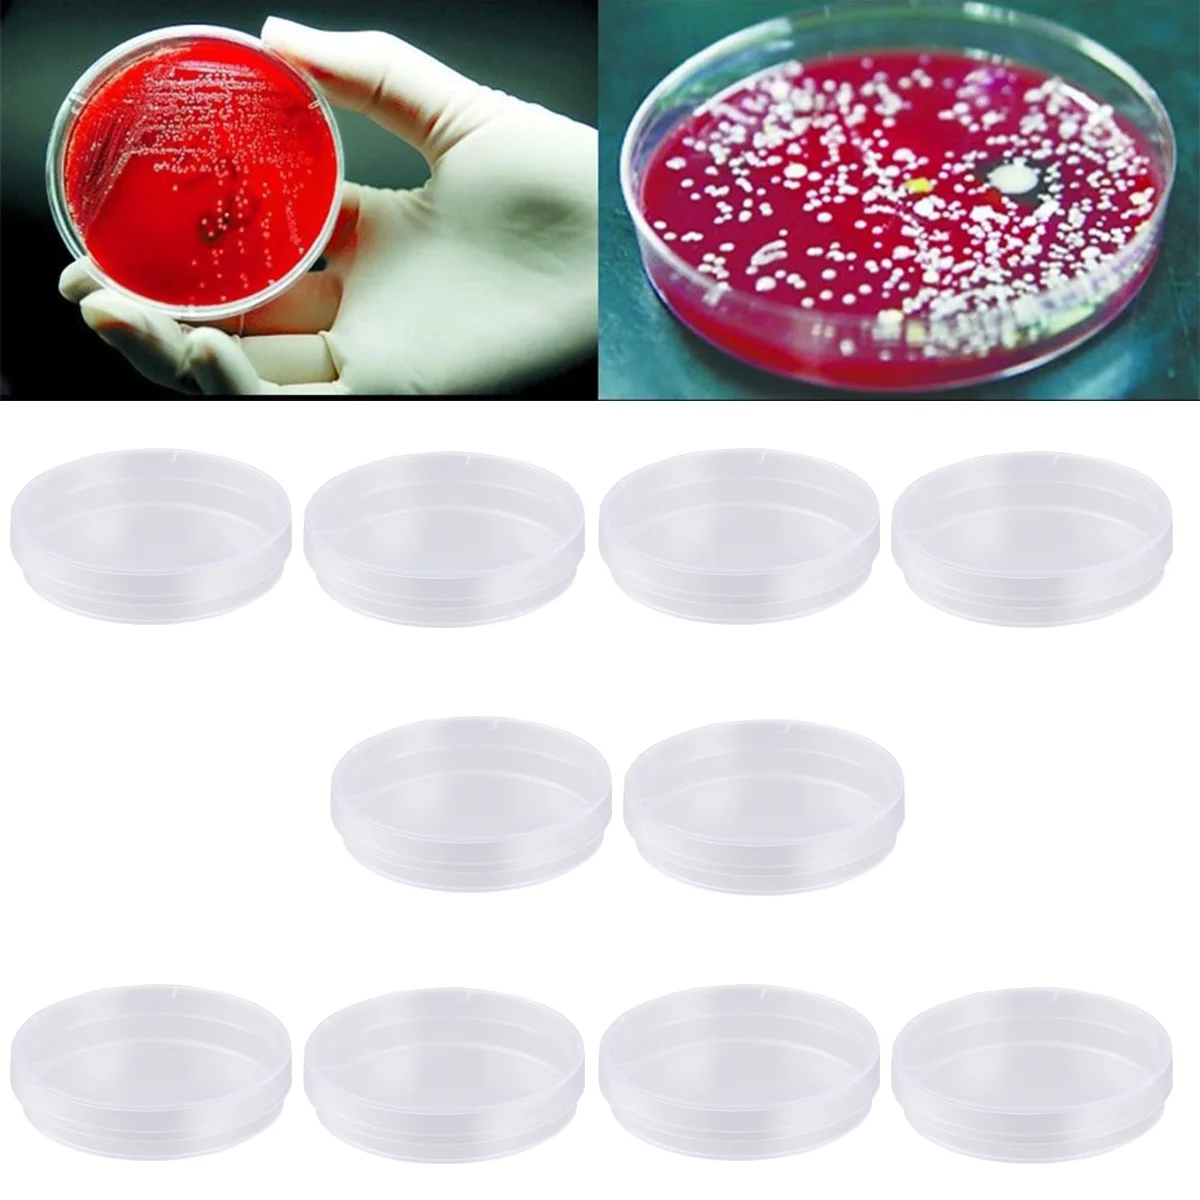

Крышки, чаши Петри с агаром с крышкой, стеклянные крышки, чаши Петри с агаром с крышкой, лабораторная чаша с крышкой
Price history chart & currency exchange rate
Customers also viewed

$10.24
Новые сексуальные трусики для ягодиц и бедер Корректирующее белье размера плюс с высокой талией и мягкой подкладкой Нижнее белье L
joom.ru
$9.26
Плюшевый брелок Дораэмон с меняющимся лицом - Мультяшный подарок и игрушка для снятия стресса
joom.ru
$2.99
20 colors solid beanies autumn winter wool blends soft warm knitted cap men women skull cap hats gorro ski caps gh1323264992, Blue;gray
dhgate.com
$200.10
2023 luxurious vacation-ready denim bag: chain-strap & fringe detailing, high-end feel in original blue fabric, perfect as travel or busines
dhgate.com
$17.01
scarves 2021 winter scarf women knit ring neck thick fur fleece letter embroidery warm outdoor sport men collar infinity snood3366982, Blue;gray
dhgate.com
$6.71
2022 New Diamond-encrusted Sunglasses European and American Handmade Glasses Fashion All-match Square Sunglasses
aliexpress.com
$62.99
CARNIVAL Automatic Mechanical Watch Men Mesh Belt Bracelet Mens Watches Small Second Dial 24 Hours Waterproof Tourbillon Clock
aliexpress.com
$2.10
Elastic Rope Yoga Sports Hair Band for Men and Women Fitness Wash Face Hair Band Headband Headband
aliexpress.com
$7.60
17CM One Piece Anime Luffy Roronoa Zoro Chinese New Year Style Action Figure Model Action Adult Toys Collection Statue Doll Gift
aliexpress.com
$45.97
Modern Led Pendant Lights Nordic Plant Hanging Lamp For Bedroom Dining Room Bar Decor Home Lighting Iron Luminaire Suspension
aliexpress.com
$12.78
2.5 Inch HDD SSD SATA Hard Disk Drive Caddy Frame Tray Bracket + Screws for HP ProBook 4340s 4540s 4545s 4740s 4445s 4440s
aliexpress.com
$9.10
1~10 PK Label Maker M21 500 499 Cartridge Black/White 12.7mm Nylon Cloth Film Use Cable&Wire Marking,Laboratory Item Labeling
aliexpress.com
$280.08
Manufacture factory high quality and inexpensive differential assembly for forklift
aliexpress.com
$7.30
Льняной бант, украшение, чехол для свадебной вечеринки, мероприятия, декор для отеля, дня рождения, столовой, банкета, кружевной спинки стула...
aliexpress.ru
$10.61
Auto Snow Chains Universal Car Snow Mud Tire Traction Mat Wheel Chain Non-slip Anti Slip Grip Tracks Tools For SUV Auto parts
aliexpress.com
$66.24
factory outlet womensr oses timulatorro seto ic vibr atornippl emassa gergpoin tvibrat orsuitabl eforclit lstimula roses ad
dhgate.com
$54.31
81 94 115cm tactical molle bag nylon gun bag rifle case military backpack for sniper airsoft holster shooting hunting accessorie q5984757
dhgate.com
$19.28
Набор аксессуаров для робота-пылесоса Ecovacs DEEBOT OZMO T8 Max T8 AIVI T8 T9 Series N8 Pro N8 Pro
aliexpress.ru
$11.92
Комплект постельного белья для девушек из 2/3 предметов, пододеяльник из полиэстера для милых девушек, король, королева, пододеяльник, мультя...
aliexpress.ru
$6.15
Мини-ящик для инструментов, деталь для багажника 1/10 RC Crawler Car Axial SCX10 Traxxas Trx4 RC4WD D90, обновленные детали, 2 шт.
aliexpress.ru
$1.11
White Green Daisy Full Cover Yellow French Short Flat Shape Toe False Nails DIY Foot Tips Nail Art Manicure Salon Material
aliexpress.ru
$76.30
Модное асимметричное платье Fuschia для выпускного вечера длинное вечернее платье без бретелек атласное платье на молнии сзади
aliexpress.ru
$28.00
Lexon carbon Bicycle Stem Mountain Road Bike Stem Ultralight Stem 31.8mm Handlebar Stem 0 Degree 35mm Bike Stem
aliexpress.ru
$14.90
EONKO Super Bass Multi Function Radio Speaker Bluetooth AM FM TF USB AUX Handsfree Recording Flashlight Colck Alarm Clock Type C
aliexpress.ru
$3.65
20x For BMW X4 Series F26 Logo Car Wheel Hub Sticker Car Personality Decorative Auto Accessories High Reflective Stripe Tape
aliexpress.ru
$5.94
Женский ремень, Женский корсет для тренировки, однотонный корсет со шнуровкой и ремешками, корсет с поддержкой груди для девушек, боди
aliexpress.ru
$957.28
Folding electric bike adult electric bicycle high carbon steel e bicycle for parent and child 12 inch 48V 350W e bike
aliexpress.com
$64.78
IRINAQ119 Spring Summer 2021 Original Design New Arrivals Vintage V Neck Printed Robe Dress Long
aliexpress.com
$91.37
Thickening men's T-shirt long-sleeved youth casual solid color round neck sweater Plus fertilizer XL t-shirt 9137
aliexpress.com